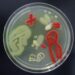
The Cholesterol Cure Found In Your Gut

The Miracle Cure Hidden In Plain Sight
Experts emphasize the accessibility and numerous health benefits of walking as an exercise option for people of all fitness levels. Dr. James McDeavitt, a professor at Baylor College of Medicine, underscores the simplicity of incorporating walking into daily life, making it a convenient and effective choice for improving overall well-being. He highlights its positive impact on heart health, mental wellness, and bone strength, making it an ideal exercise for individuals seeking to enhance their physical activity.
Walking is particularly advantageous for those with joint issues or mobility impairments, as it imposes less stress on the body compared to high-impact activities like running. Indoor walking tracks provide a safe environment, especially when accompanied by a caregiver or loved one, offering an accessible option for individuals with limited mobility. However, caution is advised when using automated cardio machines like treadmills, especially for those with severe mobility issues, due to the risk of injury.
McDeavitt recommends starting with short daily walks of five to ten minutes for beginners and gradually increasing duration over time. He emphasizes the importance of maintaining a low intensity over a longer period for maximum benefit, although picking up the pace can also intensify the workout. Additionally, McDeavitt suggests focusing on proper footwear, with shoes featuring sturdy soles, ample cushioning, and ankle support to ensure comfort and stability during walks.
Incorporating a variety of exercises into one’s routine can further enhance the benefits of walking. McDeavitt advises adding resistance and strength training with weights to improve bone health and overall cardiovascular fitness. By diversifying physical activities, individuals can optimize their workout regimen and achieve better overall well-being. Overall, walking serves as an accessible and effective form of exercise, offering numerous health benefits for people of all ages and fitness levels.

Discussion about this post